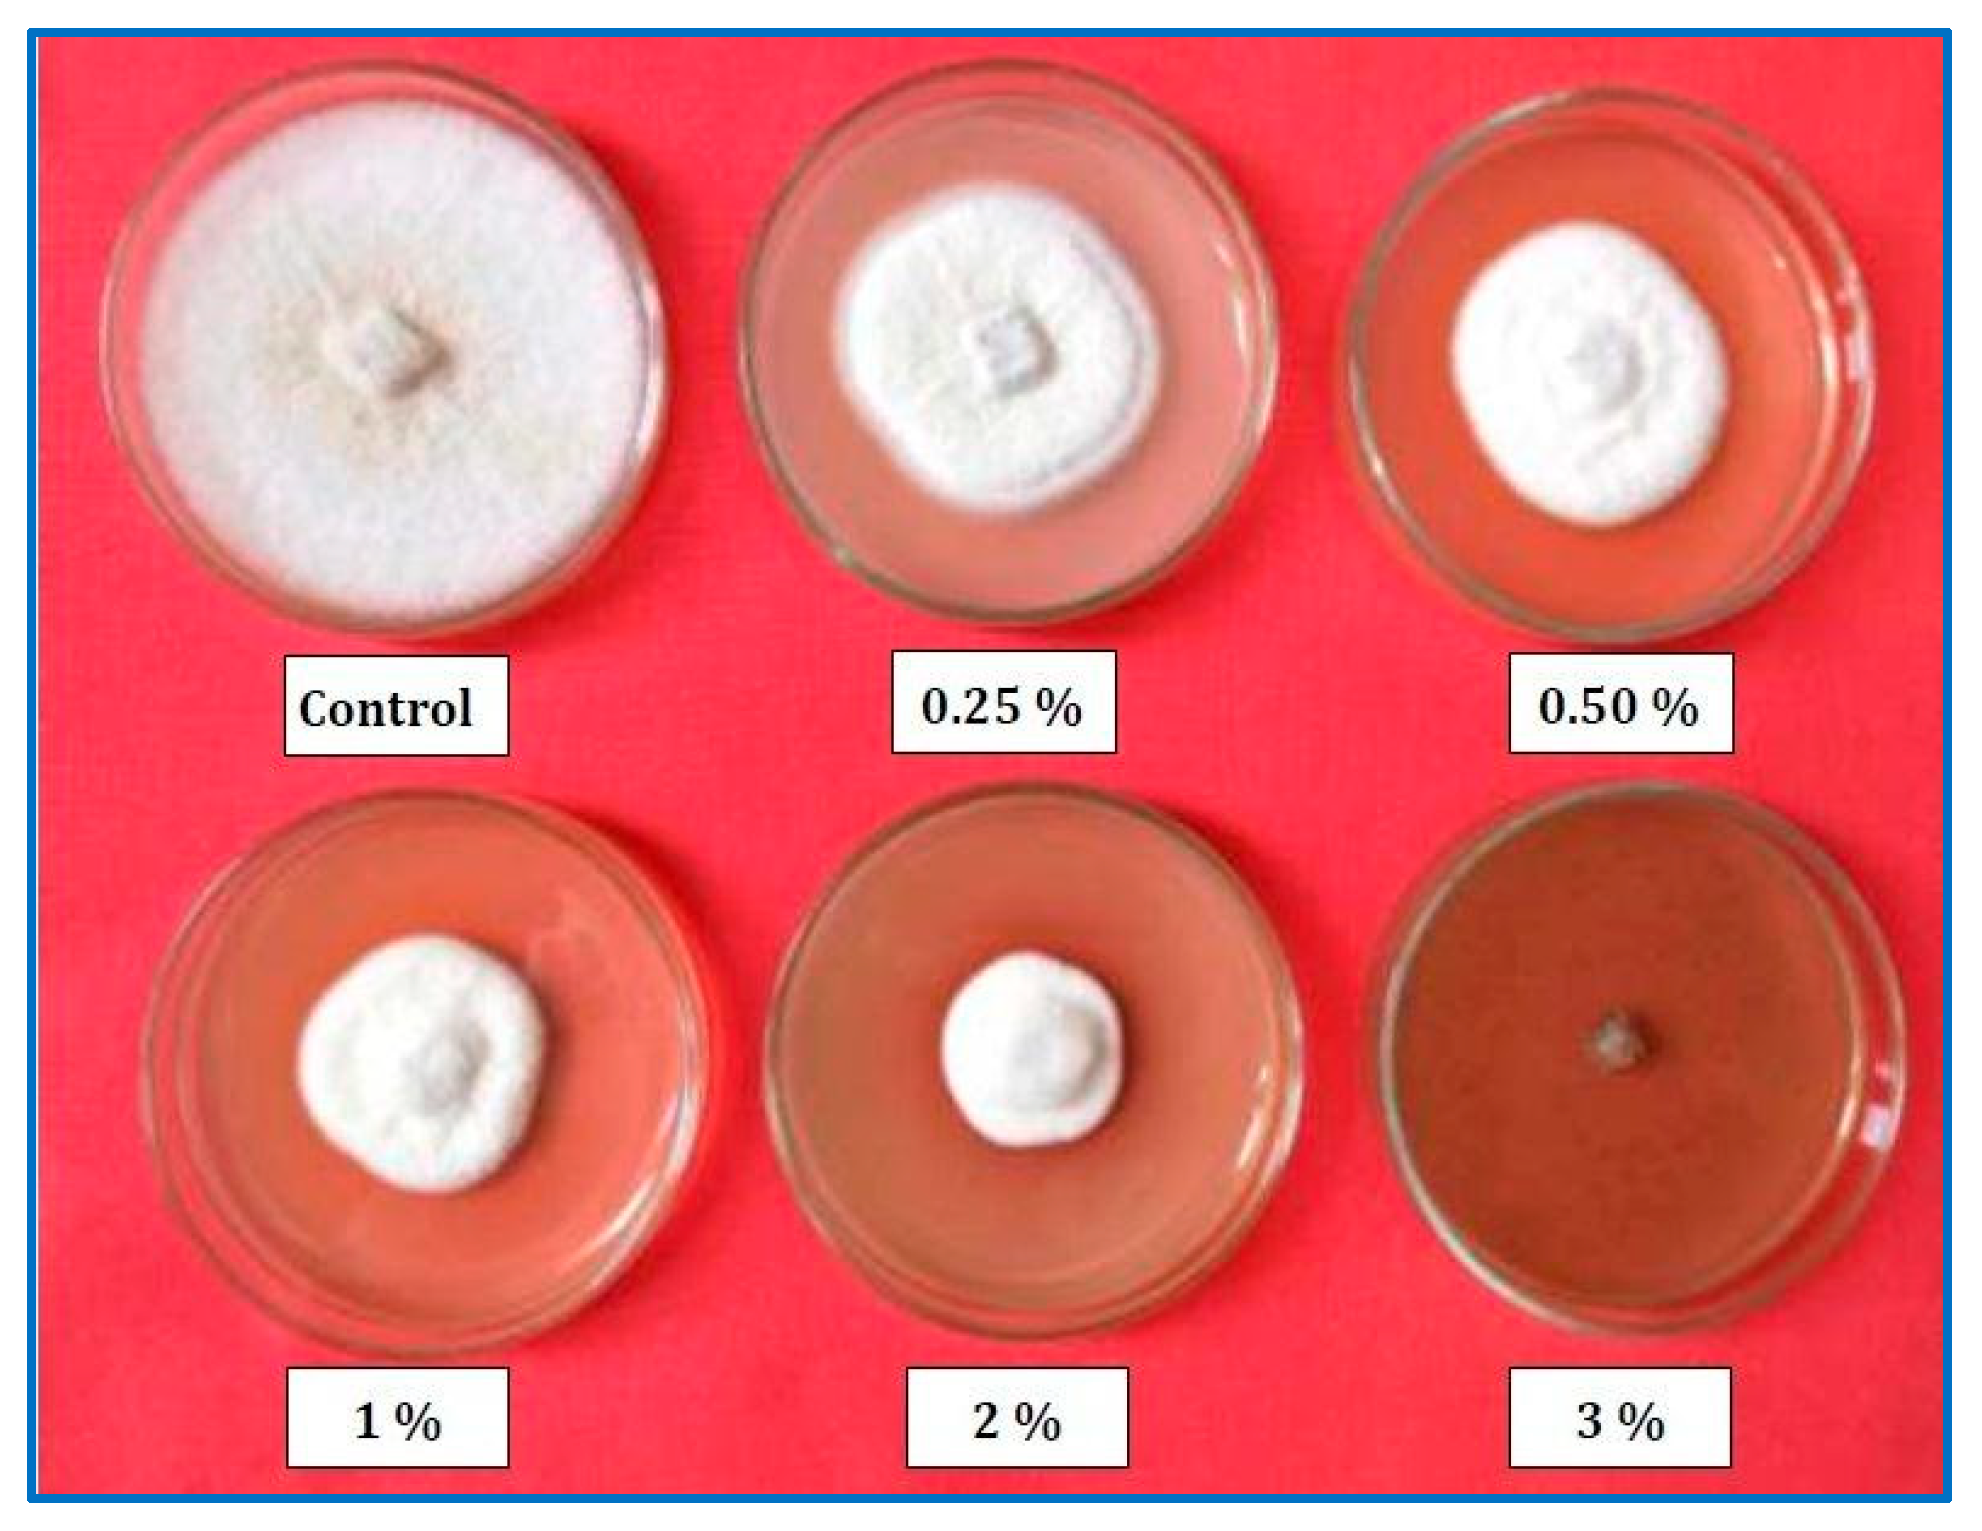
Horticulturae 09 00710 g005 Horticulturae 09 00710 g005

Fungicidal Effect of Guava Wood Vinegar against Colletotrichum coccodes Causing Black Dot Disease of Potatoes
Abstract
1. Introduction
2. Materials and Methods
2.1. Fungal Isolation and Identification
2.2. Pathogenicity Test
2.2.1. Plant Material
2.2.2. Inoculum Preparation
2.2.3. Plants Inoculation
2.2.4. Disease Assessment
2.3. Antifungal Activity
2.3.1. Guava Wood Vinegar Production
2.3.2. Analysis of the Chemical Composition of Guava Wood Vinegar by GC–MS
2.3.3. Plate Assays
2.3.4. Greenhouse Experiments
2.4. Statistical Analysis
3. Results
3.1. Isolation and Identification of the Pathogen
3.2. Pathogenicity of C. coccodes Isolate on Potato Plants
3.3. Chromatographic Analysis of Guava WV
3.4. Plate Assays
3.5. Greenhouse Experiments
3.6. Effects of Guava Wood Vinegar on Plant Growth and Tuber Yield of Potato
4. Discussion
Author Contributions
Funding
Data Availability Statement
Acknowledgments
Conflicts of Interest
References
- Lees, A.K.; Hilton, A.J. Rewiev, black dot (Colletotrichum coccodes): An increasingly important disease of potato. Plant Pathol. 2003, 52, 3–12. [Google Scholar] [CrossRef]
- Mohan, S.K.; Davis, J.R.; Sorensen, L.H.; Schneider, A.T. Infection of aerial parts of potato plants by Colletotrichum coccodes and its effects on premature vine death and yield. Am. Potato J. 1992, 69, 547–559. [Google Scholar] [CrossRef]
- Johnson, D.A.; Miliczky, E.R. Effects of wounding and wetting duration on infection of potato foliage by Colletotrichum coccodes. Plant Dis. 1993, 77, 13–17. [Google Scholar] [CrossRef]
- Johnson, D.A. Effect of foliar infection caused by Colletotrichum coccodes on yield of Russett Burbank potato. Plant Dis. 1994, 78, 1075–1078. [Google Scholar] [CrossRef]
- Andrivon, D.; Lucas, J.M.; Guerin, C.; Jouan, B. Colonization of roots, stolons, tubers and stems of various potato (Solanum tuberosum) cultivars by the black dot fungus Colletotrichum coccodes. Plant Pathol. 1998, 47, 440–445. [Google Scholar] [CrossRef]
- Andrivon, D.; Ramage, K.; Guerin, C.; Lucan, M.; Jouan, B. Distribution and fungicide sensitivity of Colletotrichum coccodes in French potato-producing areas. Plant Pathol. 1997, 46, 722–728. [Google Scholar] [CrossRef]
- Dickson, B.T. The black dot disease of potato. Phytopathology 1926, 16, 23–40. [Google Scholar]
- El-Marzoky, H.A. First record of black dot disease caused by Colletotrichum coccodes on potato plants in Egypt. Egypt. J. Phytopathol. 2013, 41, 69–84. [Google Scholar] [CrossRef]
- Griffiths, H.M.; Zitter, T.A.; Loeffler, K.; De Jong, W.S.; Menasha, S. First report in North America of atypical symptoms caused by Colletotrichum coccodes on field-grown potato tubers during storage. Plant Health Prog. 2010, 11, 46. [Google Scholar] [CrossRef]
- Anonim. Wood vinegar. In Forest Energy Forum, 9; FAO of United Nations: Rome, Italy, 2001. [Google Scholar]
- Guillen, M.D.; Manzanos, M.J. Study of the volatile composition of an aqueous oak smoke preparation. Food Chem. 2002, 79, 283–292. [Google Scholar] [CrossRef]
- Aguirre, J.L.; Baena, J.; Martin, M.T.; Nozal, L.; Gonzalez, S.; Manjon, J.L.; Peinado, M. Composition, ageing and herbicidal properties of wood vinegar obtained through fast biomass pyrolysis. Energies 2020, 13, 2418. [Google Scholar] [CrossRef]
- Grewal, A.; Abbey, L.; Gunupuru, L.R. Production, prospects and potential application of pyroligneous acid in agriculture. J. Anal. Appl. Pyrolysis 2018, 135, 152–159. [Google Scholar] [CrossRef]
- Zulkarami, B.; Ashrafuzzaman, M.; HusniIsmail, M.R. Effect of pyroligneous acid on growth, yield and quality improvement of rock melon in soilless culture. Aust. J. Crop. Sci. 2011, 5, 1508–1514. [Google Scholar]
- Obeng, J.; Agyei-Dwarko, D.; Teinor, P.; Danso, I.; Lutuf, H.; Lekete-Lawson, E.; Ablormeti, F.K.; Eddy-Doh, M.A. Bioactivity of an organic farming aid with possible fungistatic properties against some oil palm seedling foliar pathogens. Sci. Rep. 2023, 13, 1280. [Google Scholar] [CrossRef] [PubMed]
- Najafi-Ghiri, M.; Boostani, H.R.; Hardie, A.G. Investigation of biochars application on potassium forms and dynamics in a calcareous soil under different moisture conditions. Arch. Agron. Soil Sci. 2022, 68, 325–339. [Google Scholar] [CrossRef]
- Sivaram, A.K.; Panneerselvan, L.; Mukunthan, K.; Megharaj, M. Effect of pyroligneous acid on the microbial community composition and Plant Growth-Promoting Bacteria (PGPB) in soils. Soil Syst. 2022, 6, 10. [Google Scholar] [CrossRef]
- Fengel, D.; Wegener, G. Wood: Chemistry, Ultrastructure, Reactions; Walter de Gruyter: Berlin, Germany, 1983. [Google Scholar]
- Yatagai, M.; Nishimoto, M.; Hori, K.; Ohira, T.; Shibata, A. Termiticidal activity of wood vinegar, its components and their homologues. J. Wood Sci. 2002, 48, 338–342. [Google Scholar] [CrossRef]
- Yodthong, B.; Jirasak, T.; Nuethip, D.; Yaowalak, S.; Nuanchai, K. Utilization of wood vinegars as sustainable coagulating and antifungal agents in the production of natural rubber sheets. J. Environ. Sci. Tech. 2008, 1, 157–163. [Google Scholar] [CrossRef]
- Mao, Q.; Zhao, Z.; Ma, X. Preparation, toxicity and components analysis of apricot branch wood vinegar. J. Northwest A F Univ.-Nat. Sci. Ed. 2009, 37, 91–96. [Google Scholar]
- Jung, K.H. Growth inhibition effect of pyroligneous acid on pathogenic fungus, Alternaria mali, the agent of Alternaria blotch of apple. Biotechnol. Bioproc. Eng. 2007, 12, 318–322. [Google Scholar] [CrossRef]
- Chuaboon, W.; Ponghirantanachoke, N.; Athinuwat, D. Application of wood vinegar for fungal disease controls in paddy rice. Appl. Environ. Res. 2016, 38, 77–85. [Google Scholar] [CrossRef]
- Hwang, Y.; Matsushita, Y.; Sugamoto, K.; Matsui, T. Antimicrobial effect of the wood vinegar from Crytomeria japonica sapwood on plant pathogenic microorganisms. J. Microbiol. Biotechnol. 2005, 15, 1106–1109. [Google Scholar]
- Velmurugan, N.; Chun, S.S.; Han, S.S.; Lee, Y.S. Characterization of Chikusaku-eki and Mokusaku-eki and its inhibitory effect on sapstaining fungal growth in laboratory scale. Int. J. Environ. Sci. Technol. 2009, 6, 13–22. [Google Scholar] [CrossRef]
- Bridgewater, A.V. Biomass fast pyrolysis. Thermal Sci. 2004, 8, 21–50. [Google Scholar] [CrossRef]
- Kadota, M.; Niimi, Y. Effects of charcoal with pyroligneous acid and barnyard manure on bedding plants. Sci. Hortic. 2004, 101, 327–332. [Google Scholar] [CrossRef]
- Cowan, M.M. Plant products as antimicrobial agents. Clin. Microbiol. Rev. 1999, 12, 564–582. [Google Scholar] [CrossRef]
- Saberi, M.; Askary, H.; Sarpeleh, A. Integrated effects of wood vinegar and tea compost on root rot and vine decline and charcoal root rot diseases of muskmelon. Biocontrol Plant Protect. 2013, 1, 91–101. [Google Scholar] [CrossRef]
- Nakayama, F.S.; Vinyard, S.H.; Chow, P.; Bajwa, D.S.; Youngquist, J.A.; Muehl, J.H.; Krzysik, A.M. Guayule as a wood preservative. Ind. Crop. Prod. 2001, 14, 105–111. [Google Scholar] [CrossRef]
- Mu, J.; Yu, Z.M.; Wu, W.Q.; Wu, Q.L. Preliminary study of application effect of bamboo vinegar on vegetable growth. For. Study China 2006, 8, 43–47. [Google Scholar] [CrossRef]
- Jothityangkoon, D.; Ruamtakhu, C.; Tipparak, S.; Wanapat, S.; Polthanee, A. Using wood vinegar in increasing rice productivity. In Proceedings of the 2nd International Conference on Rice for the Future, Bangkok, Thailand, 5–9 November 2007; pp. 28–34. [Google Scholar]
- Sutton, B.C. The genus Glomerella and its anamorph Colletotrichum. In Colletotrichum: Biology, Pathology and Control; Bailey, J.A., Jeger, M.J., Eds.; CAB International: Wallingford, UK, 1992; pp. 1–26. [Google Scholar]
- Rehman, F.; Lee, S.K.; Kim, H.S.; Jeon, J.H.; Park, J.; Joung, H. Dormancy breaking and effects on tuber yield of potato subjected to various chemicals and growth regulators under greenhouse conditions. J. Biol. Sci. 2001, 1, 818–820. [Google Scholar] [CrossRef]
- Abdel-Hafez, S.I.I.; Abo-Elyousr, K.A.M.; Abdel-Rahim, I.R. Fungicidal activity of extracellular products of cyanobacteria against Alternaria porri. Eur. J. Phycol. 2015, 50, 239–245. [Google Scholar] [CrossRef]
- Perez-Mora, J.L.; Cota-Rodriguez, D.A.; Rodriguez-Palafox, E.E.; Garcia-Leon, E.; Beltran-Pena, H.; Lima, N.B.; Tovar-Pedraza, J.M. First confirmed report of Colletotrichum coccodes causing black dot on potato in Mexico. J. Plant Dis. Prot. 2020, 127, 269–273. [Google Scholar] [CrossRef]
- Nitzan, N.; Evans, M.A.; Cummings, T.F.; Johnson, D.A.; Batchelor, D.L.; Olsen, C.; Haynes, K.G.; Brown, C.R. Field resistance to potato stem colonization by the black dot pathogen Colletotrichum coccodes. Plant Dis. 2009, 93, 1116–1122. [Google Scholar] [CrossRef] [PubMed]
- Senthilkumar, R.; Manivannan, R.; Balasubramanian, A.; Rajkapoor, B. Antioxidant and hepatoprotective activity of ethanol extract of Indigofera trita Linn. On CCl4 induced hepatoxicity in rats. J. Pharmacol. Toxicol. 2008, 3, 344–350. [Google Scholar] [CrossRef]
- Zhang, T.; Xu, Y.; Li, J. Inhibitory effect of wood vinegar produced from apricot shell on Aspergillus fumigatus. Agric. Biotechnol. 2018, 7, 112–115. [Google Scholar]
- MSTAT-C. A Software Program for the Design, Management and Analysis of Agronomic Research Experiments; Michigan State University: East Lansing, MI, USA, 1991; p. 400. [Google Scholar]
- Gomez, K.A.; Gomez, A.A. Comparison between treatment means. In Statistical Procedures for Agricultural Research; Lviley, A., Ed.; Interscience Publication: New York, NY, USA, 1984; pp. 187–680. [Google Scholar]
- Li, Z.; Zhang, Z.; Wu, L.; Zhang, H.; Wang, Z. Characterization of five kinds of wood vinegar obtained from agricultural and forestry wastes and identification of major antioxidants in wood vinegar. Chem. Res. Chin. Univ. 2019, 35, 12–20. [Google Scholar] [CrossRef]
- Ikergami, F.; Sekin, T.; Fuji, Y. Antidemaptophyte activity of phenolic compounds in Mokusaku-eki. Yakugaku Zasshi 1992, 118, 27–30. [Google Scholar] [CrossRef]
- Yang, J.F.; Yang, C.H.; Liang, M.T.; Gao, Z.J.; Wu, Y.W.; Chuang, L.Y. Chemical composition, antioxidant, and antibacterial activity of wood vinegar from Litchi chinensis. Molecules 2016, 21, 1150. [Google Scholar] [CrossRef]
- Soares, J.M.; da Silva, P.F.; Puton, B.M.S.; Brustolin, A.P.; Cansian, R.L.; Dallago, R.M.; Valduga, E. Antimicrobial and antioxidant activity of liquid smoke and its potential application to bacon. Innov. Food Sci. Emerg. Technol. 2016, 38, 189–197. [Google Scholar] [CrossRef]
- Saloko, S.; Darmadji, P.; Setiaji, B.; Pranoto, Y. Antioxidative and antimicrobial activities of liquid smoke nanocapsules using chitosan and maltodextrin and its application on tuna fish preservation. Food Biosci. 2014, 7, 71–79. [Google Scholar] [CrossRef]
- Desvita, H.; Faisal, M.; Mahidin, M.; Suhendrayatna, S. Preliminary study on the antibacterial activity of liquid smoke from cacao pod shells (Theobroma cacao L.). IOP Conf. Ser. Mater. Sci. Eng. 2021, 1098, 022004. [Google Scholar] [CrossRef]
- Morey, A.; Bratcher, C.L.; Singh, M.; dan McKee, S.R. Effect of liquid smoke as an ingredient in frankfurters on Listeria monocytogenes and quality attributes. Poult. Sci. J. 2012, 91, 2341–2350. [Google Scholar] [CrossRef]
- Chukeatirote, E.; Jenjai, N. Antimicrobial activity of wood vinegar from dimocarpus longan. Environ. Asia 2018, 11, 161–169. [Google Scholar] [CrossRef]
- Desvita, H.; Faisal, M.; Mahidin, M.; Suhendrayatna, S. Antimicrobial potential of wood vinegar from cocoa pod shells (Theobroma cacao L.) against Candida albicans and Aspergillus niger. Mater. Today Proc. 2022, 63, S210–S213. [Google Scholar] [CrossRef]
- Oramahi, H.A.; Yoshimura, T. Antifungal and antitermitic activities of wood vinegar from Vitex pubescens Vahl. J. Wood Sci. 2013, 59, 344–350. [Google Scholar] [CrossRef]
- Steiner, C.; Das, K.C.; Garcia, M.; Forster, B.; Zech, W. Charchoal and smoke extract stimulate the soil microbial community in highly weathered xanthic Ferralsol. Pedobiologia 2007, 51, 359–366. [Google Scholar] [CrossRef]
- Quan, S. Application of wood vinegar to control diseases. J. Agric. Sci. Yanbian Univ. 1994, 2, 113–116. [Google Scholar]
- Yuan, F.; Zhang, C.; Shen, Q.R. Allevating effect of phenol compounds on cucumber Fusarium wilt and mechanism. Agric. Sci. China 2003, 2, 647–652. [Google Scholar]
- Saberi, M.; Sarpeleh, A.; Askary, H. Management of damping-off and increasing of dome growth traits of cucumber in greenhouse culture using citrus wood vinegar. Appl. Res. Plant Prot. 2015, 4, 99–111. [Google Scholar]
- Wei, Q.; Ma, X.; Zhao, Z.; Zhang, S.; Liu, S. Antioxidant activities and chemical profiles of pyroligneous acids from walnut shell. J. Anal. Appl. Pyrolysis 2010, 88, 149–154. [Google Scholar] [CrossRef]
- Zhang, L.; Wang, L.D.; Gong, W. Chemical constituents and antibacterial activity of Jujube kernel vinegar. Food Sci. 2016, 37, 123–127. [Google Scholar]
- Zhu, K.; Gu, S.; Liu, J.; Luo, T.; Khan, Z.; Zhang, K.; Hu, L. Wood vinegar as a complex growth regulator promotes the growth, yield, and quality of rapeseed. Agronomy 2021, 11, 510. [Google Scholar] [CrossRef]
- Wang, Y.; Qiu, L.; Song, Q.; Wang, S.; Wang, Y.; Ge, Y. Root proteomics reveals the effects of wood vinegar on wheat growth and subsequent tolerance to drought stress. Int. J. Mol. Sci. 2019, 20, 943. [Google Scholar] [CrossRef] [PubMed]
- Lin, K.; Ye, F.; Lin, Y.; Li, Q. Research progress on the mechanism of phenolic substances on soil and plants. J. Eco-Agric. 2010, 5, 1130–1137. [Google Scholar]
- Yan, Y.; Lu, X.; Li, L.; Zheng, J.; Pan, G. The composition of straw pyrolysis wood vinegar and its effect on the growth and quality of pepper. J. Nanjing Agric. Univ. 2011, 5, 58–62. [Google Scholar]
- Fedeli, R.; Vannini, A.; Grattacaso, M.; Loppi, S. Wood distillate (pyroligneous acid) boosts nutritional traits of potato tubers. Ann. Appl. Biol. 2023, 1–6. [Google Scholar] [CrossRef]
- Fanfarillo, E.; Fedeli, R.; Fiaschi, T.; de Simone, L.; Vannini, A.; Angiolini, C.; Loppi, S.; Maccherini, S. Effects of wood distillate on seedling emergence and first-stage growth in five threatened arable plants. Diversity 2022, 14, 669. [Google Scholar] [CrossRef]

| Retention Time (min.) | Compound Name | Molecular Formula | Molecular Weight | Area % |
|---|---|---|---|---|
| 6.44 | 2-Cyclopenten-1-one | C5H6O | 82 | 2.39 |
| 8.29 | Butyrolactone | C4H6O2 | 86 | 5.74 |
| 9.57 | 2-Cyclopenten-1-one, 3-methyl- | C6H8O | 96 | 2.12 |
| 9.86 | Phenol | C6H6O | 94 | 4.32 |
| 10.31 | 1-Cyclopentylethanone | C7H12O | 112 | 2.03 |
| 11.05 | Cyclotene | C6H8O2 | 112 | 4.59 |
| 12.34 | P-Cresol | C7H8O | 108 | 3.52 |
| 12.91 | Guaiacol | C7H8O2 | 124 | 12.82 |
| 16.75 | 2-Methoxy-5-methylphenol | C8H10O2 | 138 | 3.13 |
| 17.28 | Catechol | C6H6O2 | 110 | 3.83 |
| 24.83 | 2,6-Dimethoxyphenol | C8H10O3 | 154 | 16.12 |
| 28.84 | 1,2,4-Trimethoxybenzene | C9H12O3 | 168 | 6.39 |
| 31.91 | 1,2,3-Trimethoxy-5-(methoxymethyl) benzene | C10H14O3 | 182 | 5.58 |
| 43.31 | 9, 12, 15-Octadecatrienoic acid, 2-phenyl-1, 3-dioxan-5-yl ester | C28H40O4 | 440 | 0.61 |
| 51.97 | Ethyl iso-allocholate | C26H44O5 | 436 | 0.04 |
| Treatments | Disease Severity Index (%) | |||||
|---|---|---|---|---|---|---|
| Season 2021 | Season 2022 | |||||
| SC% * | RCS% ** | Wilt% | SC% | RCS% | Wilt% | |
| guava WV 2% | 25.63 ± 1.90 b | 23.33 ± 10.00 b | 33.33 ± 9.43 b | 23.14 ± 1.62 b | 26.67 ± 7.63 b | 33.33 ± 33.34 b |
| guava WV 3% | 20.16 ± 1.70 c | 20.00 ± 5.77 c | 22.22 ± 19.05 c | 21.91 ± 1.80 c | 23.33 ± 2.89 b | 33.33 ± 33.34 b |
| Amistar 25% | 15.33 ± 1.42 d | 16.67 ± 2.89 d | 11.11 ± 19.05 d | 18.312 ± 1.51 d | 13.33 ± 5.77 c | 22.22 ± 19.24 c |
| Inoculate and untreated control | 60.41 ± 2.30 a | 63.33 ± 5.77 a | 55.56 ± 19.23 a | 73.15 ± 2.10 a | 73.33 ± 11.55 a | 66.67 ± 19.24 a |
| LSD at 0.05 | 0.65 | 11.04 | 5.43 | 0.52 | 15.26 | 6.27 |
| Treatments | Growing Season 2021 | Growing Season 2022 | ||||
|---|---|---|---|---|---|---|
| Plant Height (cm) | Stem Diameter (mm) | Tuber Yield/Pot (g) | Plant Height (cm) | Stem Diameter (mm) | Tuber Yield/Pot (g) | |
| Guava WV 2%; | 32.00 ± 1.53 b | 10.33 ± 1.53 a | 243.52 ± 6.88 b | 34.00 ± 1.00 ab | 10.33 ± 2.08 b | 248.55 ± 2.99 b |
| Guava WV 3%; | 38.67 ± 3.06 a | 11.00 ± 1.00 a | 274.52 ± 5.45 a | 38.00 ± 2.65 a | 11.33 ± 1.15 a | 281.72 ± 6.85 a |
| Amistar 25%; | 30.33 ± 4.04 b | 10.33 ± 0.58 a | 208.67 ± 2.31 cd | 31.67 ± 3.51 bc | 10.00 ± 1.00 b | 211.67 ± 2.89 cd |
| Inoculated and untreated control; | 21.67 ± 1.53 c | 7.67 ± 1.16 b | 195.16 ± 6.01 d | 22.67 ± 2.08 d | 7.33 ± 0.58 c | 198.45 ± 8.06 d |
| Uninoculated and untreated control; | 27.00 ± 1.00 b | 9.67 ± 1.16 a | 215.29 ± 9.52 c | 29.00 ± 1.73 c | 9.33 ± 1.53 b | 227.38 ± 4.93 c |
| LSD at 0.05 | 5.24 | 1.50 | 17.07 | 4.50 | 1.14 | 20.45 |
Disclaimer/Publisher’s Note: The statements, opinions and data contained in all publications are solely those of the individual author(s) and contributor(s) and not of MDPI and/or the editor(s). MDPI and/or the editor(s) disclaim responsibility for any injury to people or property resulting from any ideas, methods, instructions or products referred to in the content. |
© 2023 by the authors. Licensee MDPI, Basel, Switzerland. This article is an open access article distributed under the terms and conditions of the Creative Commons Attribution (CC BY) license (https://creativecommons.org/licenses/by/4.0/).
Share and Cite
El-Fawy, M.M.; Abo-Elyousr, K.A.M.; Sallam, N.M.A.; El-Sharkawy, R.M.I.; Ibrahim, Y.E. Fungicidal Effect of Guava Wood Vinegar against Colletotrichum coccodes Causing Black Dot Disease of Potatoes. Horticulturae 2023, 9, 710. https://doi.org/10.3390/horticulturae9060710
El-Fawy MM, Abo-Elyousr KAM, Sallam NMA, El-Sharkawy RMI, Ibrahim YE. Fungicidal Effect of Guava Wood Vinegar against Colletotrichum coccodes Causing Black Dot Disease of Potatoes. Horticulturae. 2023; 9(6):710. https://doi.org/10.3390/horticulturae9060710
Chicago/Turabian StyleEl-Fawy, Mansour M., Kamal A. M. Abo-Elyousr, Nashwa M. A. Sallam, Rafeek M. I. El-Sharkawy, and Yasser Eid Ibrahim. 2023. "Fungicidal Effect of Guava Wood Vinegar against Colletotrichum coccodes Causing Black Dot Disease of Potatoes" Horticulturae 9, no. 6: 710. https://doi.org/10.3390/horticulturae9060710
APA StyleEl-Fawy, M. M., Abo-Elyousr, K. A. M., Sallam, N. M. A., El-Sharkawy, R. M. I., & Ibrahim, Y. E. (2023). Fungicidal Effect of Guava Wood Vinegar against Colletotrichum coccodes Causing Black Dot Disease of Potatoes. Horticulturae, 9(6), 710. https://doi.org/10.3390/horticulturae9060710

